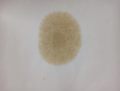

Skoda Octavia 1.8 tsi mt
Skoda Octavia 2016, двигатель бензиновый 1.8 л, 240 л. с., передний привод, механическая коробка передач — отзыв владельца
Альбом 7

Отзыв владельца
Пришел и мой черед сменить авто. Если честно покупку планировал на год позже, но когда увидел какой рестайлинг ждет октавию, было решено срочно закрывать этот вопрос). Рассматривал только 1.8 и только на ручке. DSG7 даже не обсуждалась, дизель так же отпал, RS дорого.
В итоге имеем комплектацию Style с пакетом Elegance+ (ксенон, парктроники в круг, вебасто и бесключевой доступ), диски Denom R17 (очень нравится как выглядит на них), розетка и допы от дилера (тонировка, газовые упоры, ковры и т.д. — все по делу, лишнего не напихали).
Первые впечатления — супер :) Жаль обкатка — оценить все в полной мере получится только весной. Пока практически не езжу на ней, свою приору выставил на продажу, в силу времени года и отсутствия зимней резины на октавии передвигаюсь по больше части на тазу). Естественно после отечественного автопрома, октавия — самолет: тихая, мягкая, комфортная, ничего не скрепит, не трещит и т.д. Практически сразу заменил хром окантовку решетки радиатора на черную, чтоб её, все руки исцарапал… Как она остается у людей целой без снятия бампера я никогда не узнаю, видимо).
Планы на нее пока только строю… Возможно что-нибудь зашумим, чипанем, болерамбус запилим (под большим вопросом:). По подвеске хз, после приоры меня все устраивает). Поездим — будет видно.
Паспортные данные
- Двигатель 1.8 бензиновый, 240 л. с.
- Механическая коробка передач
- Передний привод
- Машина 2016 года выпуска, была куплена в 2017 году
- Skoda Octavia A7 Mk3 выпускается с 2012 года
Бортжурнал 38
Аксессуары

Доработки









Колёса



Наблюдения и впечатления

Неприятности


Ремонт и обслуживание











События

Разное




Машины в продаже

Skoda Octavia, 2013

Skoda Octavia, 2015

Skoda Octavia, 2018












Комментарии 47
Голос за вагобрата 🤝🏻
Из Грозного голос
Голос + подпись земляку шкодоводу. Удачи!
красавчик !
+1
+1 👏!
Давай уыиграй всех 😆
Подпись + удачи!
Удачи 👍
++
+👋
+1
Голос, удачи!
+
Приятно читать и видеть, поддержу +
Удачи
За VAG💪 удачи!
Октахе удачи на выборах ✌️
+1. Удачи!
Удачи на выборах отличный ваг 👍🏻